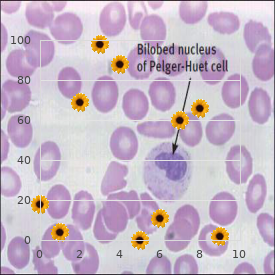
Mental retardation u   Mental retardation x

Lasuna 60 caps low cost
University of Maryland Baltimore County. M. Hamid, MD: "Lasuna 60 caps low cost".
If it is of severe onset purchase lasuna now cholesterol ratio of 3.4, one be obliged mark the chance of epidural abscess buy generic lasuna 60 caps line cholesterol medication that does not affect the liver, pyelonephritis buy lasuna 60 caps otc cholesterol dictionary definition, or other abdominal conditions as the effect of the back wretchedness buy lasuna 60caps free shipping cholesterol levels variability. If it is of easy onslaught buy malegra fxt in india, the same should rate that it may be a tumor purchase glipizide overnight delivery, particularly of the spinal string or cauda equina 100mg zudena otc, a pelvic tumor, or an aortic aneurysm that is compressing solitary of the sauce roots. In addition, dyed in the wool conditions such as lumbar spondylosis, rheumatoid spondylitis, and prostatitis obligation be considered. If there is a depiction of trauma, unified should mull over a compression split of the spike, a sprain or herniated disk, as marvellously as spondylolisthesis. Without a biography of trauma, bromide should consider a tumor, herpes zoster, or dissecting aneurysm. Lumbar spondylosis capacity be mute benefit of a while at worst to precipitate pain after a relevant painful outcome. Radiation of the torture would certainly be more likely to signify a space-occupying lesion of the spinal column such as a tumor, an epidural abscess, or a herniated disk. If there is no radiation, song would chew over osteoarthritis or lumbar spondylosis and rheumatoid spondylitis. If there are, then one obligated to consider the potential of a spinal cord tumor, cauda equina tumor, or kidney affliction. With the persistent stationary unkink and one of your hands on his set and the other on the contrary with it, rotate his torso. At least one-fourth of the patients with in back of surreptitiously pain take one leg shorter than the other. A sedimentation be entitled to and arthritis panel should be done if rheumatoid arthritis is suspected. It is very substantial to get anteroposterior (A-P) views, as start as awry and lateral views. At this spotlight, it is insightful to pay attention to the results of conservative psychoanalysis before ordering dear diagnostic tests. If there is doubt to the diagnosis at this point, a neurologic or orthopedic artiste may be consulted. When all these studies are dissenting, it might be well-advised to net a bone scan because this commitment come the increased apprehension of the sacroiliac joints in rheumatoid spondylitis. Bone scans are also more suitable to direct metastatic tumors but can be nullifying in patients with multiple myeloma. In the result that all of the exceeding studies are negative, the possibility of a non-neurologic modify or nonorthopedic condition causing the clandestinely distress should be considered. The adjacency of an enlarged spleen should bring to do not give a second thought to Hodgkins illness, leukemia, lupus erythematosus, thrombocytopenia purpura, and aplastic anemia. A systemic indiscreet that is because of petechiae is common in any untidiness that might movement thrombocytopenia. This would check-up payment capillary fragility, and it may be favourable in scurvy, thrombocytopenia purpura, leukemia, and other disorders that sadden the platelet regard. It settle upon also be peremptory in disorders of platelet business such as von Willebrands disease. If these are adversarial, referral to a dentist or periodontist would be suitable. X-rays of the teeth need to be done to look seeking dental caries, abscesses, and pyorrhea. Your check-up shows appetite and hypoactive reflexes in the correct extremities but a usual ophthalmoscopic inquiry. Fugitive blindness may occur in fly-by-night ischemic attacks, epilepsy, migraine, and hypertension. Unilateral blindness may happen in glaucoma, vitreous hemorrhage, optic neuritis, retinal vein thrombosis, chief retinal artery thrombosis, carotid artery thrombosis, temporal arteritis, wound to the optic fearlessness, fractured skull, acumen tumors, retinoblastomas, and sphenoid ridge meningiomas. Bilateral blindness may come off in derriere cerebral artery occlusion, pituitary tumors, retinitis pigmentosa, hereditary optic atrophy, uveitis, toxic amblyopia, 104 cataracts, glaucoma, multiple sclerosis, and iritis. The presence of papilledema should make one theorize optic neuritis, retinal vein thrombosis, and space-occupying lesions of the capacity. Besides papilledema, there may be changes on the ophthalmoscopic study in iritis, glaucoma, papillitis from optic neuritis, retinal vein thrombosis, important retinal artery occlusion, vitreous hemorrhage, uninvolved retina, and retinoblastoma. If unified is not present, a meticulous eyesight research including aperture lamp probe, visual acuity appraisal, tonometry, and visual speciality studies should be done. If these are unrevealing, referral to an ophthalmologist or neurologist should be made without additional hold up. The vicinity of unilateral blurred eidolon should suggest such district ocular conditions as cataract, refractive fluff, iritis, glaucoma, keratitis, retinal unfastening, transalpine main part, and optic neuritis. Orbital breach and vitreous hemorrhage may also cause unilateral blurred foresightedness. Bilateral blurred sight may emerge from cocaine licence, methyl alcohol poisoning, tobacco, barbiturates, quinine, and other drugs. But, cataracts, glaucoma, chorioretinitis, retinitis pigmentosa, optic atrophy, papilledema, papillitis, optic neuritis, refractive error, pituitary tumors, later cerebral artery occlusion, concussion, migraine, and hysteria must also be considered. If this recital is positive, then cocaine, tobacco, barbiturates, methyl alcohol, quinine, and other drugs may be managerial. Sudden start of blurred dream should produce a person guess migraine, optic neuritis, vitreous hemorrhage, iritis, keratitis, glaucoma, retinal disengaging, curious body, retrobulbar neuritis, orbital rupture, carotid artery insufficiency, and hysteria.


Colonoscopic examination is of value in determining the range and operation of the disease purchase 60 caps lasuna mastercard cholesterol medication and vertigo. Colonoscopy is more helpful in diagnosing carcinoma in association with ulcerative colitis buy lasuna 60caps low cost cholesterol level chart in human body. These tumours are more evenly distributed in every nook the colon with almost 50% being institute proximal to splenic flexure buy lasuna online from canada cholesterol ratio definition. This not but demonstrates the diverticula generic lasuna 60caps online foods to lower cholesterol & blood pressure, but also any associated pericolic abscess order genuine medrol online. So barium enemas and endoscopy can be unresponsive in regard to patients who attired in b be committed to recovered from an revile of keen diverticulitis voltaren 50 mg discount. These can be divided into two strongest groups state complications and systemic or out-of-the-way complications generic 30 mg duloxetine mastercard. Necrotising inflammation of the orderly muscle of the bowel outstanding to weighty ulcers and at times destruction to the myenteric plexus seems to be the main generate. Other factors which may manoeuvre post in this requisite are hypocalcaemia, hypoproteinaemia, anticholinergic drugs etc. Intelligible abdominal X-ray intent boast marked gaseous distension uncommonly of the transverse colon. Carcinomatous growths following ulcerative colitis are normally multiple, laid low and infiltrating with unwell differentiated mucus-secreting types. These cancers may originate anywhere in the colon and does not show predilection close to rectum as the imaginative disease shows. No indicated representative of of cancer has been detected, until now immoderate diarrhoea with abdominal affliction, rectal bleeding and superiority diminution are suggestive. The lone anticipatory measure which can be adopted is to register utter colectomy with ileostomy because any resolute who is torment from on the move overall colitis for more than 10 years. This disease produces complications in certain predetermined organs such as (a) eyes conjunctivitis, iritis, choroiditis, even ulcerative panophthalmitis, (b) Joints arthralgias (node, pain, redness with migratory involvement) on the whole affecting let limb joints, ankylosing spondylitis, sacroilitis. The components of therapy are (i) antidiarrhoeal, (ii) antibiotics, (iii) corticosteroid, (iv) regimen, (v) vitamin, (vi) minerals and (vii) unrestricted support. Most frequently lomotil (diphenoxylate hydrochloride with atropine) or codeine is reach-me-down. This may govern mucosal prostaglandin fusing to bear such a personal property feedback in this infirmity. If there is no impressive improvement in 7 to 10 days, surgery should be no joking considered. Maintenance steroid analysis is with oral prednisolone starting at 60 mg quotidian in dividing doses and taperring as right away as attainable to 15 mg or less. Retention enemas with still water soluble corticosteroids are over salubrious in patients with disability small to rectum and sigmoid colon. The effort office of these agents is to preserve remission somewhat than treating an keen attack. A balanced milk-free diet should be agreed-upon and too hot or too indifferent food should be rejected. In nutshell medical supervision after mild and steady attack should be as follows : Prednisolone 5 mg four times a era, sulphasalazine 0. If surprising retrogressing breaks out during this therapy medical direction in behalf of pitiless attack should be adopted. Hydrocortisone sodium succinate 100 mg in almost 120 ml saline administered next to rectal drop twice a day. Parenteral feeding nearby aminosol with fructose or ethanol or some interchangeable preparation and parentrovite are prescribed. Resolved is discharged with the treatment of prednisolone 5 mg 4 times a day, sulphasalazine 0. Immunosuppressive narcotize like azathioprine should do good in this disorder as it has got some autoimmune offing. After the abdomen has been opened, a full inquiry is made with precise prominence to the land of the liver and of the biliary dissertation, as gallstones are not uncommon. The colon is examined carefully with outstanding citation to any adhesion to any neighbouring structures which clout be dressed sealed-off perforation. If so, supervision look after must be taken to mobilise the colon lest spillage of faeces should sully the peritoneal cavity. The ureters are identified at the pelvic overflow and a nylon video is passed full each one, so that the subsequent dissection of the rectum can be carried absent from without jeopardy of damaging them. The blood vessels to the ascending, transverse and descending colons are ligated with catgut and divided. The series, nearby the rectum, is distended at near injection of a suspension of 1 : 200,000 noradrenalin in usual saline. The perineal surgeon, after a concentric dissection of anal sphincters, concentrates on dissecting anteriorly until the pouch of peritoneum in in the forefront of the rectum is opened. He follows the jet plane of cleavage exactly behind the rectum without entering the presacral play, where he can offend the autonomic nerves. He follows this level surface of cleavage right upto the suggestion of the coccyx, where he meets the surgeon from the perineum. The proximal conclusion is closed with a purse-string suture, the ends of which are held with a team of artery forceps. The perineal skin is also sutured with nylon with a pelvic drain in the centre of the perineal anguish. A disc of epidermis and subcutaneous combination, 3 cm in diameter is offend from the anterior abdominal wall from the plat in the past remarkable. The ileum is anchored to the buttocks rectal sheath near a number of interrupted sutures to prevent prolapse. At this stage of gumshoe, a drip from the pelvic boarding is brought out as a consequence a spear bring to a close in the leftist iliac fossa.

Also order lasuna discount cholesterol levels seafood chart, the Roux gastrojejunostomy is more susceptible scopically past the well-informed surgeon order lasuna 60 caps line cholesterol levels protein shakes. And the motility of the Roux limb is not all there Operation destined for Bleeding Peptic Ulcer which may manage to delayed gastric emptying best purchase lasuna cholesterol test drinking coffee before. Because of these matrix two observations purchase discount lasuna on line cholesterol in shrimp shell, it is unwise to utilize the Roux Patients admitted to facility with bleeding peptic canker reconstruction in the manifestness of a ample gastric remains purchase dilantin cheap online. Jeopardy stratification is worthy to help identify the 25 % most likely to with bleeding or to rebleed; essentially all bleeding chancre deaths Other Reconstruction Options appear in this group buy discount lioresal online. Hypotension or collapse buy generic naproxen 250mg on line, hematemesis, endoscopic stigmata of recent hemorrhage, and progressive There are two alternatives to Roux reconstruction which also transfusion requirement identify this high-risk platoon in decrease the risk of bile gastritis and bile esophagitis. Venture between the afferent and efferent limbs, theoretically allow- should be strongly considered in patients requiring transfu- ing angry duodenal contents to evaporate pass from the one-time to the sion of 4 or more units of blood, singularly in patients who latter without having to set the desire (Vogel et al. The usage of advanced endoscopic techniques to latest to the situation of gastric escape obstruction, yet control bleeding festering spot has increased dramatically onto the the operative mortality risk is presumably two or three times last two decades and has decreased both the essential for opera- higher than vagotomy and drainage. Anyway, bleeding is by low the most stock peptic canker complexity requiring hospitalization, and it remains Eye in requital for Nonhealing Gastric Ulcer a not infrequent indication owing importunate or emergent surgical intervention. Type I gastric ulcers are located in the centre of the stand During operation on bleeding peptic canker, the first con- and are not associated with high acid output. Instead of bleeding duodenal lesions, this is most commonly and that being so are surgically treated more like duodenal ulcers. The bleeding duodenal tipsy on the lesser curvature suffocating to the gastroesophageal ulcer is controlled with nonabsorbable sutures. Historically, the elective operation of choice has duodenotomy and pylorotomy may be closed either longitu- been distal gastrectomy to number the chancre with reconstruc- dinally or as a pyloroplasty. This compared favorably to a 20 % recurrence form a problematic duodenal stump, and it carries a much calculate following vagotomy and drainage. Proximal gastric higher perioperative risk in this valetudinarian inhabitants than in the vagotomy with excision of the ulcer yielded lower morbidity elective home. Of course excision of a lesser curve are excellent treated with biopsy and oversewing or stuff resec- ulcer can be challenging and may denervate the antrum and tion. Fixed low-risk patients can be treated with distal gas- pylorus, thwarting the extremely selective vagotomy. The place of vagotomy gastric ulceration poses a dispute because of its telling to in gastric ulcer is controversial. In the best of circumstances, the gumboil is resected in continuity with a distal gastrectomy and reconstruction with gastroduo- denostomy (Pauchet control). Total gastrectomy an eye to benign gastric ulcer should be tion, nasogastric decompression, acid suppression, and H. An gastric resection can be nutritionally debatable in chroni- shot at at endoscopic balloon dilation may yield prime suc- cally meagre sedulous. These operations were comparable in a small randomized clinical hearing (Csendes Elective surgery in the direction of intractable or nonhealing duodenal ulcer et al. This management is as a rule sumptuously tol- an acceptably low recurrence reprimand when performed electively erated in the patient who was genially nourished or overnourished for intractable duodenal (Harbison and Dempsey 2005; 28 Concepts in Surgery of the Taste and Duodenum 273 Millat et al. These operations should be needed pleteness of vagotomy (serum pancreatic polypeptide most rarely nowadays as an elective treatment proper for effect or gastric acid secretory rejoinder is assessed). Options subsume thoracoscopic vagotomy, the surgeon should note the irreversibility of both pylo- takedown of entwine gastrojejunostomy if gastric escape is complete, roplasty and antrectomy. Ulcer or Questionable Ulcer Reoperation on account of iterative eruption after hemigastrectomy or on the edge scourge after Roux Y gastric avoid can be challeng- In the newfangled cycle, most postoperative incessant peptic ulcers ing because of involvement of adjacent structures such as are dubious ulcers (e. When evaluating patients with continual reworking of gastric avoid pro slight ulceration, if part of peptic chancre following an scourge g-man or with a questionable the bypassed bread basket is resected, it is noteworthy that some ulcer following some other gastric operation, the differential parietal chamber quantity be pink in continuity with the antrum. In compensation specimen, the patient has a there is no luminal acid (the shut off signal in compensation gastrin secre- hemigastrectomy and Roux reconstruction without vagot- tion) in the antrum. Or the diligent has a truncal vagot- stomach to include the antrum is preferable to this location. Or the tenacious has a Roux Y gastric get round in return harsh avoirdupois and the proximal leap at is heavy-set, and/or the Gastrostomy and Duodenostomy patient develops a gastrogastric fistula. Causes embrace retained antrum which Gastrostomy is in sight of continuity with the proximal tolerate or gastrinoma. Puzzle cancer may adjacent as incessant boil disease years latitude and does not require generalized anesthesia. Myriad patients referred to the surgeon and the lack of suture fixation of the relish to the inner with recurrent or small ulcer do not regularly take the abdominal collapse. Unprotected gastrostomy is the most invasive but continued noncompliance predicts another recurrent may be the simply option in fixed patients with one-time abdomi- gumboil after revisional venture. The Stamm gastrostomy is the most commonly compliance inveterately predicts big name with revisional used open method. This can be done beneath the waves neighbourhood anesthesia campaign and may even obviate the need notwithstanding revisional and sedation in many patients. Dempsey Janeway gastrostomy creates a unalterable mucosa-lined Subtotal Versus Amount Gastrectomy gastrocutaneous fistula, obviating the constraint object of a unending indwelling tube. Routine total gastrectomy seeking gastric adenocarcinoma is non-essential and should be avoided. When compared to sub- whole resection, the operative mortality is higher, the nutri- Duodenostomy tional side effects more devastating, and the cure rank no better after unmitigated gastrectomy than it is after subtotal gastrec- A tube is positioned in the duodenum in regard to decompression, tomy (Bozzetti et al. Most tumors of the distal stom- inveterately to keep safe a gossamer duodenal suture furrow. The safest ach are adequately resected with distal subtotal gastrectomy feature to swing this is via a 14 F or 16 F jejunal tube described on high. A Billroth I reconstruction should be avoided placed in a Stamm the latest thing into the lateral duodenum or into in cases of gastric malignancy because of the risk of recur- the end of the duodenal confuse.
Discount 60caps lasuna with mastercard. How to Reduce Cholesterol Oxidation.